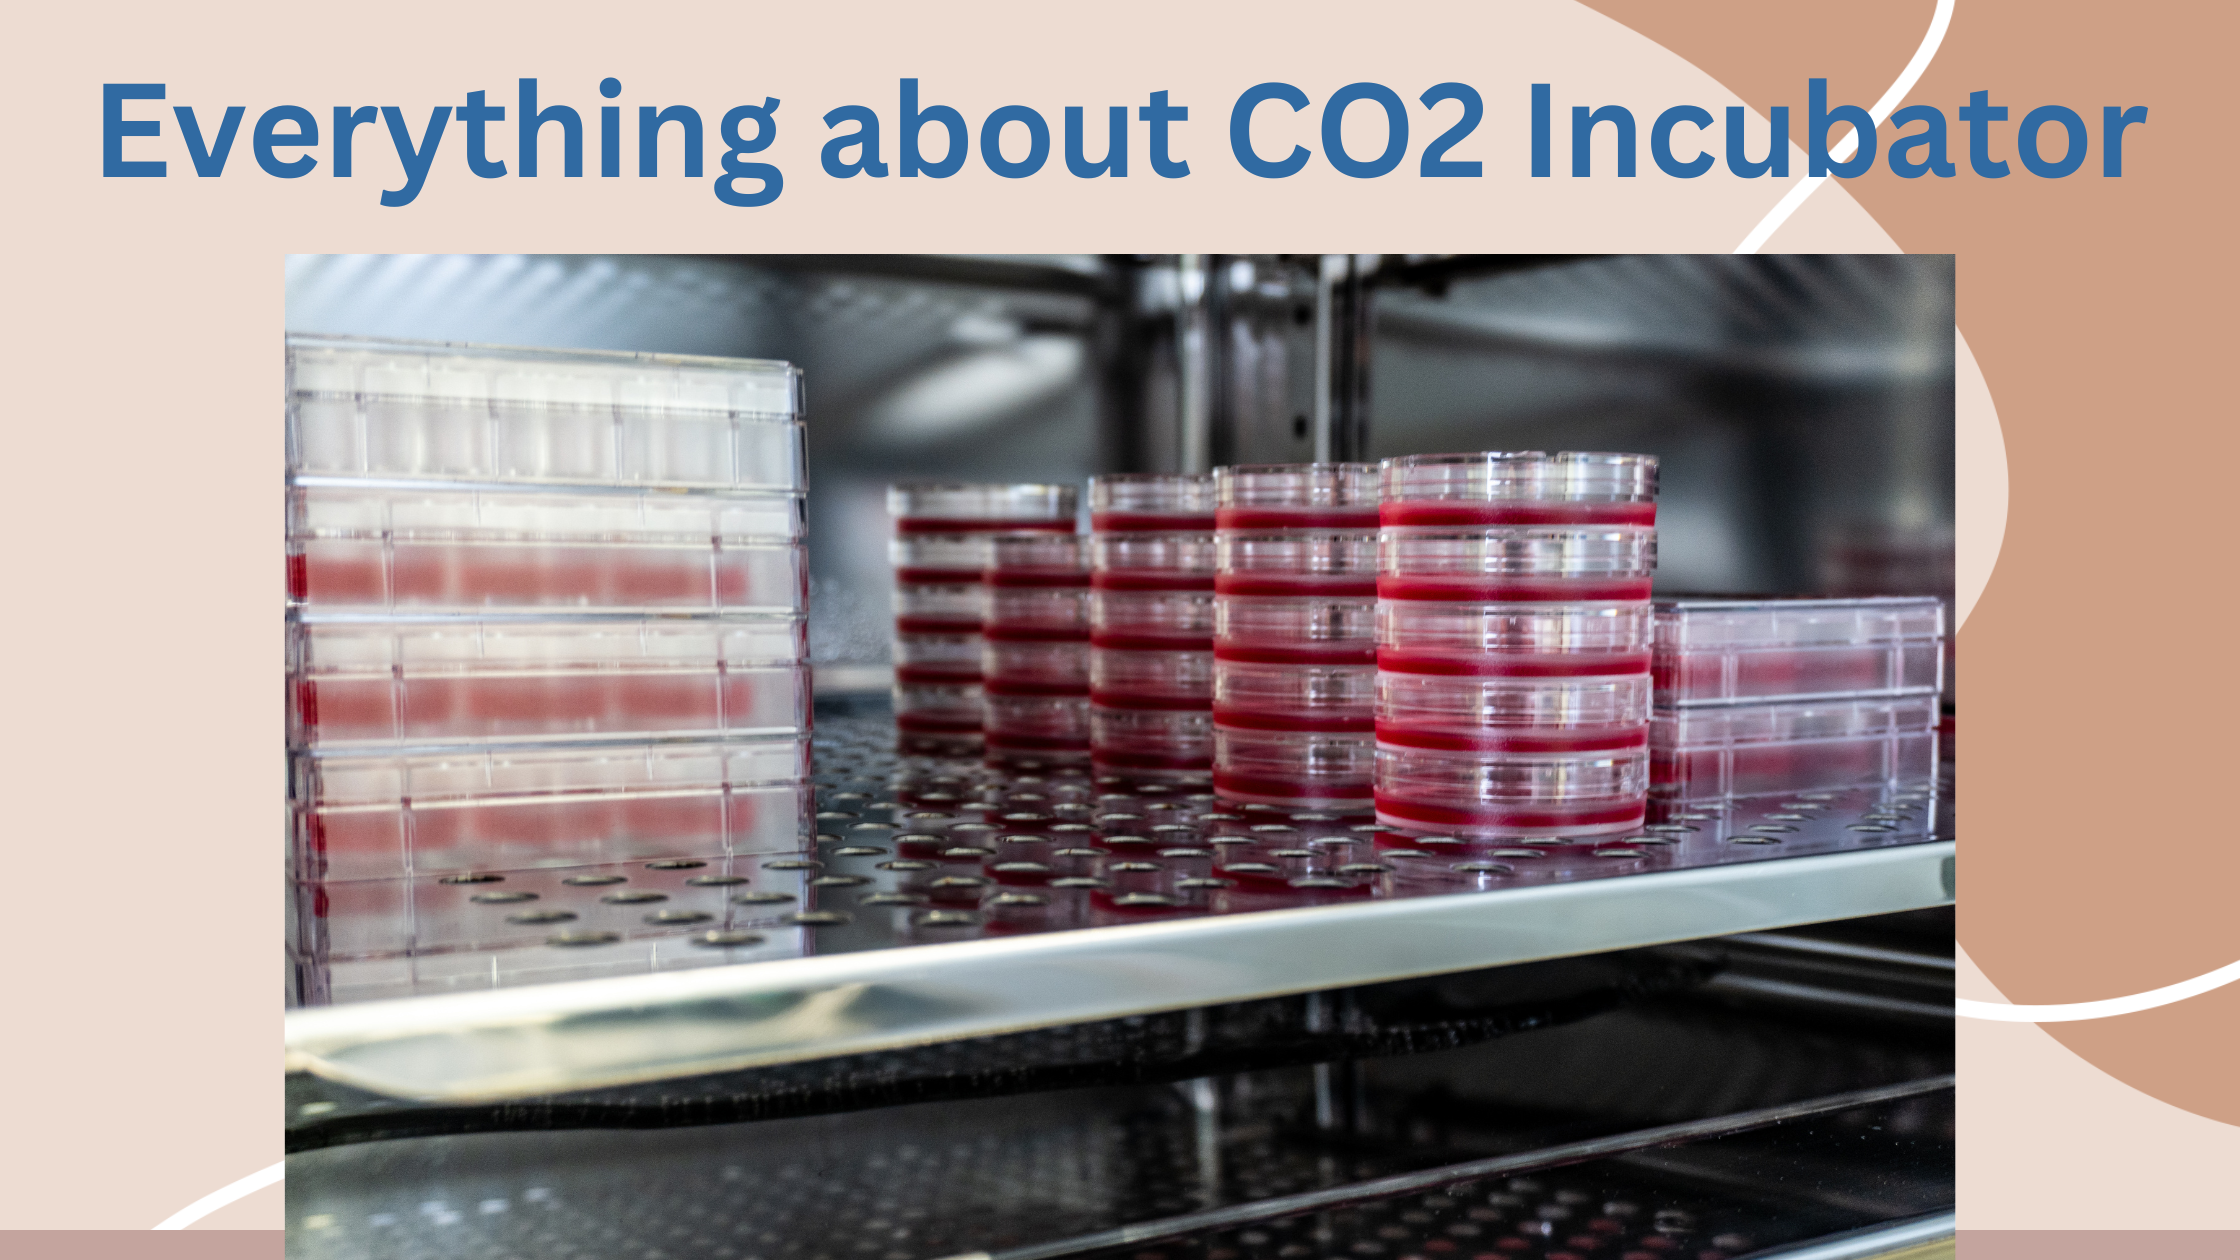
Everything About CO2 Incubator

For an incubator CO2 is the most common in biology and microbiology labs, hence used worldwide. It is also often employed in the pharmaceutical industry. A special feature in these incubators enables the user to regulate the level of carbon dioxide in the incubation chamber. This is necessary for good in-vitro cell culture. Any normal living thing needs a specific level of carbon dioxide in the atmosphere to function properly. This straightforward process is used in this incubator to maintain the ideal carbon dioxide level in the incubation environment. Typically, a thermal conductivity sensor or an infrared sensor is used to monitor the level of carbon dioxide inside the chamber. Cross contamination from bacteria, viruses, and fungus is the main risk of contamination within a CO2 incubator. Sterilisation can be used to limit this between samples.
Requirement of CO2 in an incubator
The medium that cells develop in must maintain a pH of zero for optimal cell growth settings (around pH 7). By adding more CO2, the cells' H2O can be converted into a carbonic acid (H2CO3) buffer. Bicarbonate (HCO3-) and H2CO3, which maintain a pH of 7, have been discovered to have the least impact on the development of living cells when H2O and CO2 are combined. In other words, you keep the pH within the cells from becoming either alkaline or acidic, which both impede cell development, by injecting more CO2 at the proper amount.
How to maintain CO2 and humidity levels?
With the use of precise optical nondispersive infrared (NDIR) sensors, CO2 levels within a CO2 incubator are detected. Using an NDIR CO2 sensor raises two issues:
- The sensor values must be modified in high-altitude locations to account for changes in barometric pressure.
- The sensor must be protected from excessive dampness. The CO2 sensor may become inoperable due to condensation caused by an excessive amount of water in the air.
Although a water pan is frequently used to increase humidity, when the door is opened and closed, it might lead to contamination issues and inconsistent humidity levels. Because of this, it is possible to manage the humidity level using a%RH sensor and increase it with an atomizer.
Limitations of CO2 Incubators
The limits of CO2 incubators in relation to oxygen levels is a significant area of research. Since living tissue, such as human cell cultures, flourish in air containing 20.9% oxygen, it stands to reason that this should be the ideal oxygen level within a cell incubator. Since ambient air contains 20.9% oxygen, CO2 incubators do not require airtight sealing.
The issue is that various live cell cultures develop at various oxygen levels. At oxygen concentrations between 2 and 8%, many organs operate normally. It seems sense that subjecting all cell cultures to the same 20.9% oxygen level would result in a different environment than what they would experience within the body, and thus, would alter the outcomes of cell development.
Sensors in CO2 Incubators
It's crucial to keep the CO2 level in an incubator constant. Furthermore, the CO2 sensor must function properly independent of the environment's temperature or humidity. To maintain perfect cell and tissue growth, the MicroSENS IR Incubator 0-20% CO2 Sensor, for instance, has been developed to monitor 5% by volume of CO2 in cell incubators.
This sensor is made to withstand heat and moisture, unlike normal CO2 sensors. It can tolerate heat and steam sterilisation up to 190 °C, therefore it may be fixed permanently within the incubation chamber. Additionally, it does not need to be taken back to the factory for calibration because it may be calibrated in-place.


















